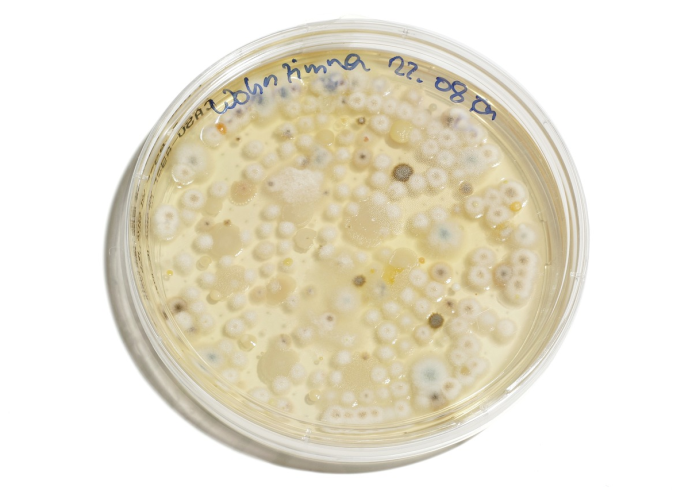
一分钟实测分享“皇豪互众在哪买房卡”房卡链接获取 一分钟实测分享“皇豪互众在哪买房卡”房卡链接获取

微信游戏中心:打开微信,添加客服【11723366】,进入游戏中心或相关小程序,搜索“怎么创建牛牛房卡房间”,选择购买方式。完成支付后,房卡会自动添加到你的账户中。
第二也可以在游戏内商城:在游戏界面中找到 “微信牛牛,斗牛链接房卡”“商城”选项,选择房卡的购买选项,根据需要选择合适的房卡类型和数量,点击“立即购买”按钮,完成支付流程后,房卡会自动充值到你的账户中。
第三方平台:除了通过微信官方渠道,你还可以在信誉良好的第三方平台上购买炸金花微信链接房卡怎么搞。这些平台通常会提供更丰富的房卡种类和更优惠的价格,但需要注意选择的平台以避免欺诈或虚假宣传。
购买步骤:皇豪互众在哪买房卡
1:打开微信,添加客服【11723366】,进入游戏中心皇豪大厅
2:搜索“皇豪大厅”,选择合适的购买方式以及套餐。
3:如果选择微信官方渠道,按照提示完成支付,支付成功后,房卡将自动添加到你的账户中。
4:如果选择第三方平台,按照平台的提示完成购买流程,确认平台的信誉和性。
5:成功后,你可以在游戏中使用房卡进行游戏。
注意事项:2025年12月02日 08时07分33秒
【央视新闻客户端】
委内瑞拉国际问题专家玛丽亚费尔南达巴雷托指出,博尔顿承认的所作所为极度无耻。
说起青海对冰雪运动的推动,多巴国家高原体育训练基地的建设是最突出的代表。
数万人看一场足球赛的氛围、团体运动的彼此鼓励、教练声情并茂的教导、队友间合作无间的互动,这些都很难在线上实现。从某种生活方式看,线上替代线下是不现实的。然而,通过这场疫情,在某些方面以线上替代线下,二者有更多的结合,将不可避免地成为未来生活的一种常态。(羊城晚报记者 周方平)
现在,研究人员正在普及这项技术。2021年,Alexandrov团队报道了SpaceM,这是一种开源软件工具,它能用光学显微镜成像数据,使用标准商用质谱仪对培养的细胞进行空间代谢组学分析[11]。他说:“我们算是做了数据分析部分的体力活。”
此外,中国在很多项目上拥有很多世界领先的水平,比如:
徐峥监制、《幕后玩家》导演任鹏远执导的犯罪片《国债风暴》在寰亚的展区首度亮相,该片取材自曾震撼整个中国证券期货界的327国债风波事件。
这番言论让拉美国家立刻想到,美国在历史上从未停止对拉美国家的盘剥,并总是以高高在上的傲慢态度贬低邻国,把自身问题嫁祸于拉美国家。当前,越来越看透美国傲慢嘴脸和霸权本质的拉美国家,正致力于摆脱美国干涉,走独立自主发展之路。
美国还制定《以制裁反击美国敌人法案》,扩大对俄罗斯、朝鲜和伊朗的制裁;启动赫尔姆斯-伯顿法第三条,加紧对古巴实施封锁,等等。美国不仅制裁被其视为敌人或竞争对手的国家,还对与这些国家有来往的第三方包括其盟友实施二级制裁,长臂肆意乱伸、疯狂挥舞。
小众也需要得到大众的关注,这样他们才能够更好的发展与传承下去。
第十二条 未经奥林匹克标志权利人许可,为商业目的擅自使用奥林匹克标志,或者使用足以引人误认的近似标志,即侵犯奥林匹克标志专有权,引起纠纷的,由当事人协商解决;不愿协商或者协商不成的,奥林匹克标志权利人或者利害关系人可以向人民法院提起诉讼,也可以请求市场监督管理部门处理。市场监督管理部门处理时,认定侵权行为成立的,责令立即停止侵权行为,没收、销毁侵权商品和主要用于制造侵权商品或者为商业目的擅自制造奥林匹克标志的工具。违法经营额5万元以上的,可以并处违法经营额5倍以下的罚款,没有违法经营额或者违法经营额不足5万元的,可以并处25万元以下的罚款。当事人对处理决定不服的,可以依照《中华人民共和国行政复议法》申请行政复议,也可以直接依照《中华人民共和国行政诉讼法》向人民法院提起诉讼。进行处理的市场监督管理部门应当事人的请求,可以就侵犯奥林匹克标志专有权的赔偿数额进行调解;调解不成的,当事人可以依照《中华人民共和国民事诉讼法》向人民法院提起诉讼。

暂时没有评论,来抢沙发吧~